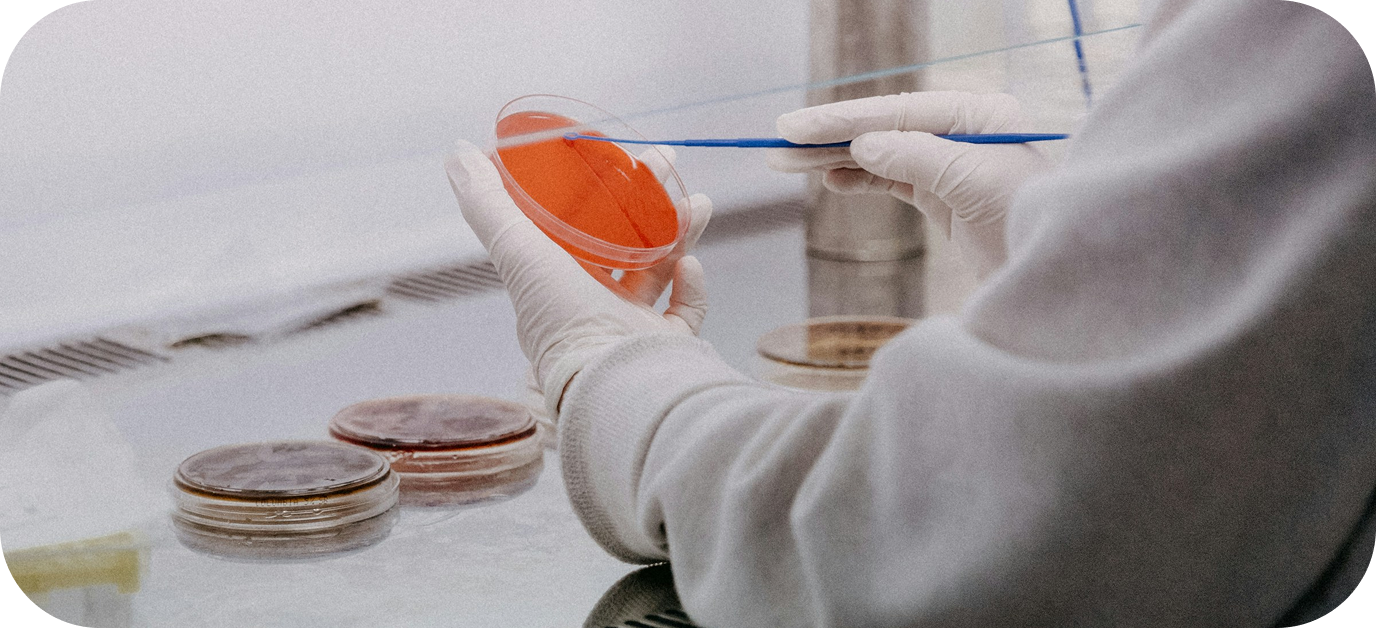

About Lorem Company
Lorem ipsum dolor sit amet consectetur. Eget facilisis elementum ultrices varius elementum ultrices elementum. Id hendrerit nec eu non. Vehicula velit vitae viverra vestibulum commodo erat faucibus odio porttitor. Turpis odio cras pellentesque purus congue odio sagittis pellentesque.
Lorem ipsum dolor sit amet consectetur. Eget facilisis elementum ultrices varius elementum ultrices elementum. Id hendrerit nec eu non. Vehicula velit vitae viverra vestibulum commodo erat faucibus odio porttitor. Turpis odio cras pellentesque purus congue odio sagittis pellentesque.
- Lorem ipsum
Lorem ipsum dolor sit amet consectetur. Eget facilisis elementum ultrices varius elementum ultrices elementum. Id hendrerit nec eu non. Vehicula velit vitae viverra vestibulum commodo erat faucibus odio porttitor.
Why Lorem Ispum Is The Right Choice For You
- Lorem ipsum
Lorem ipsum dolor sit amet consectetur. Eget facilisis elementum ultrices varius elementum ultrices elementum. Id hendrerit nec eu non. Vehicula velit vitae viverra vestibulum commodo erat faucibus odio porttitor.
- Lorem ipsum